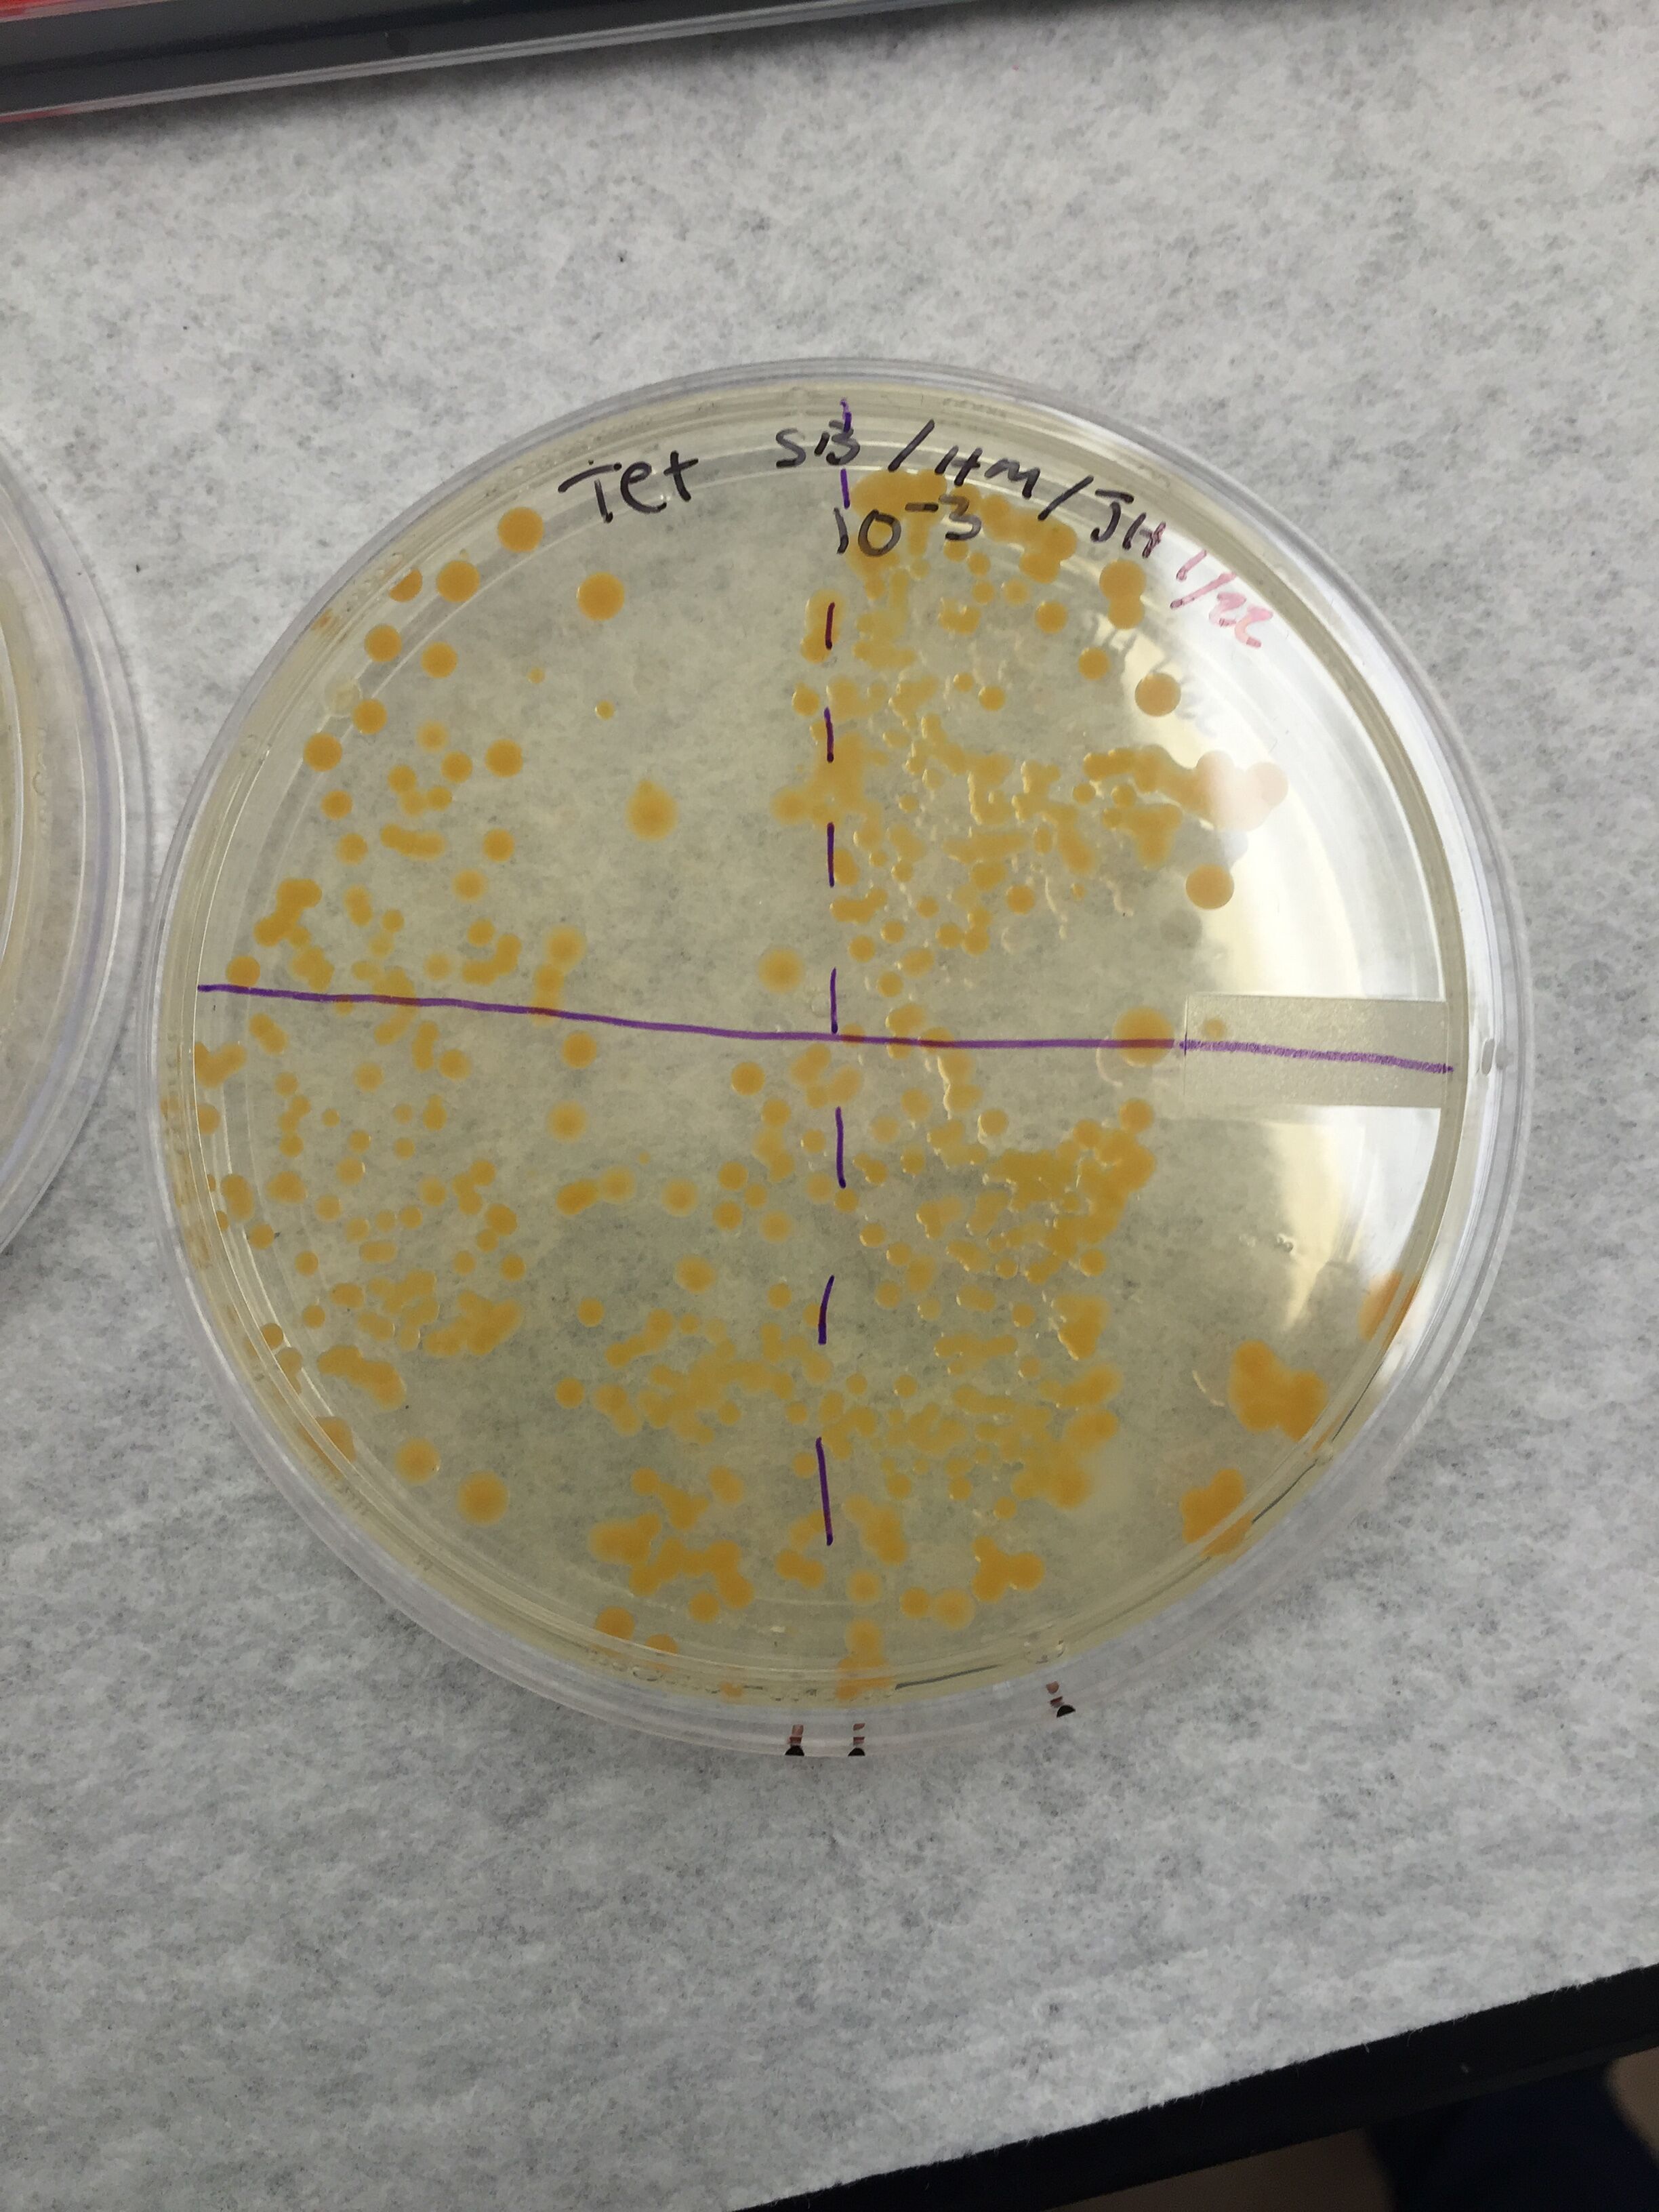
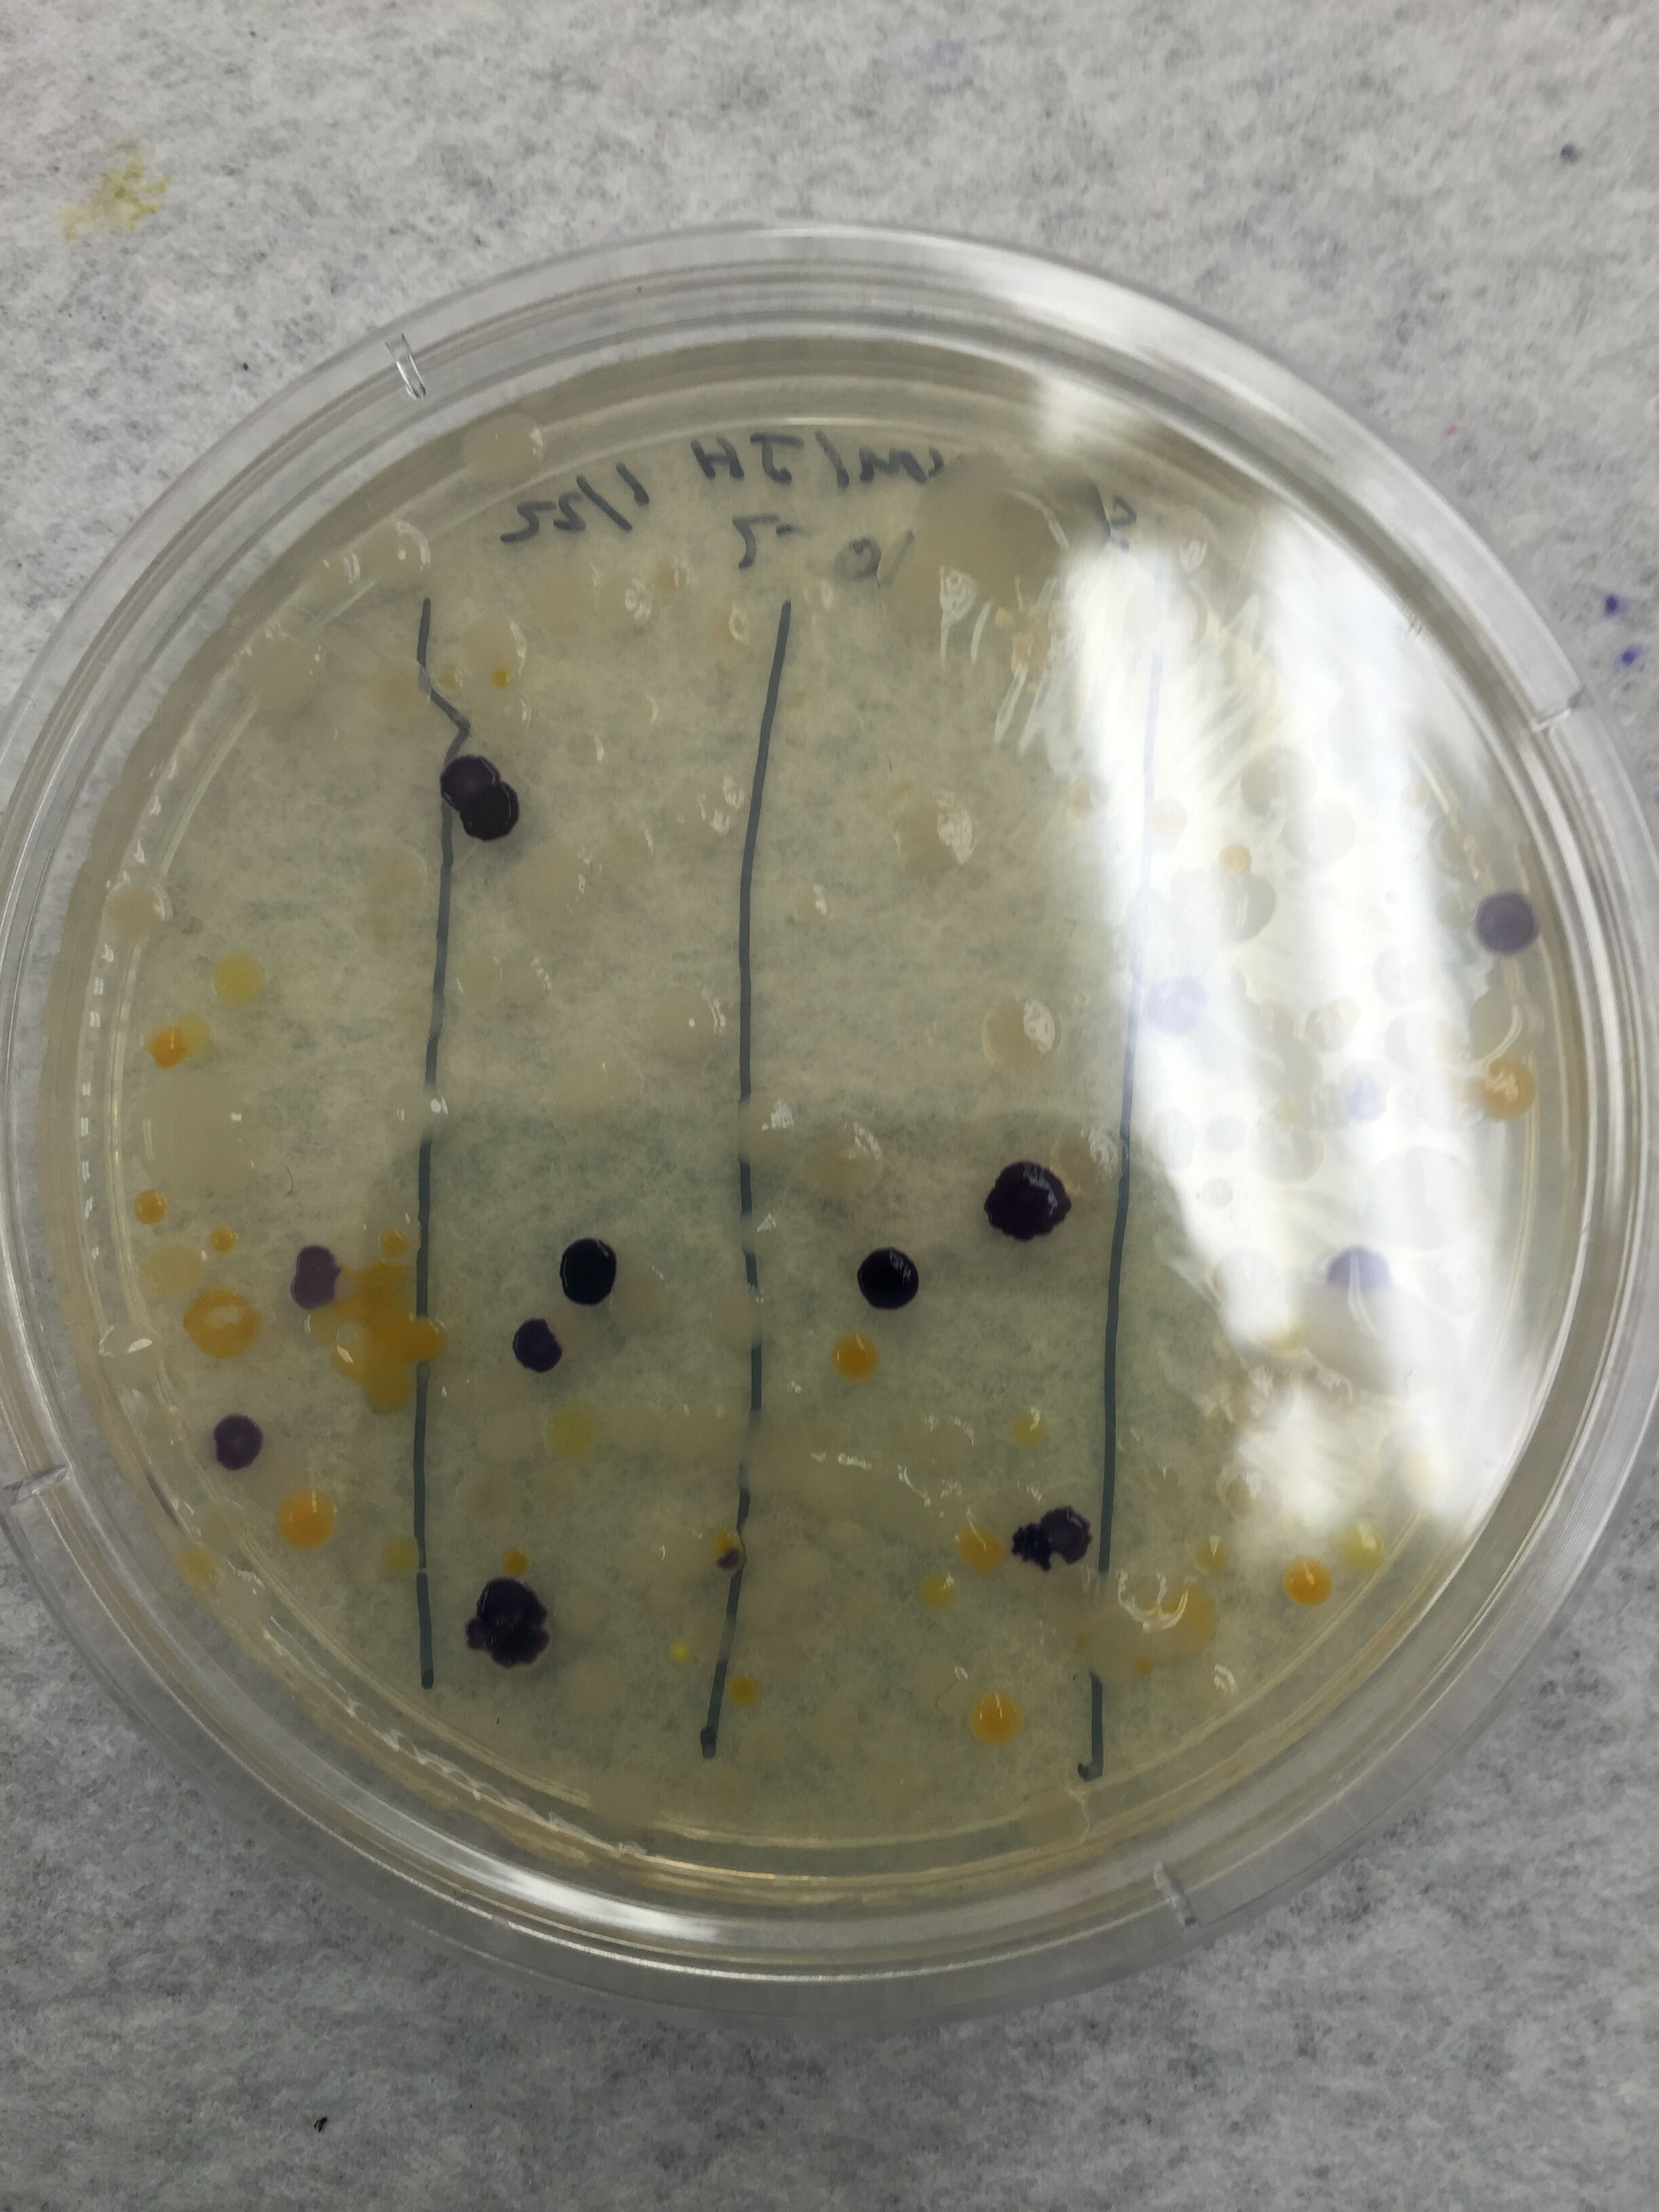
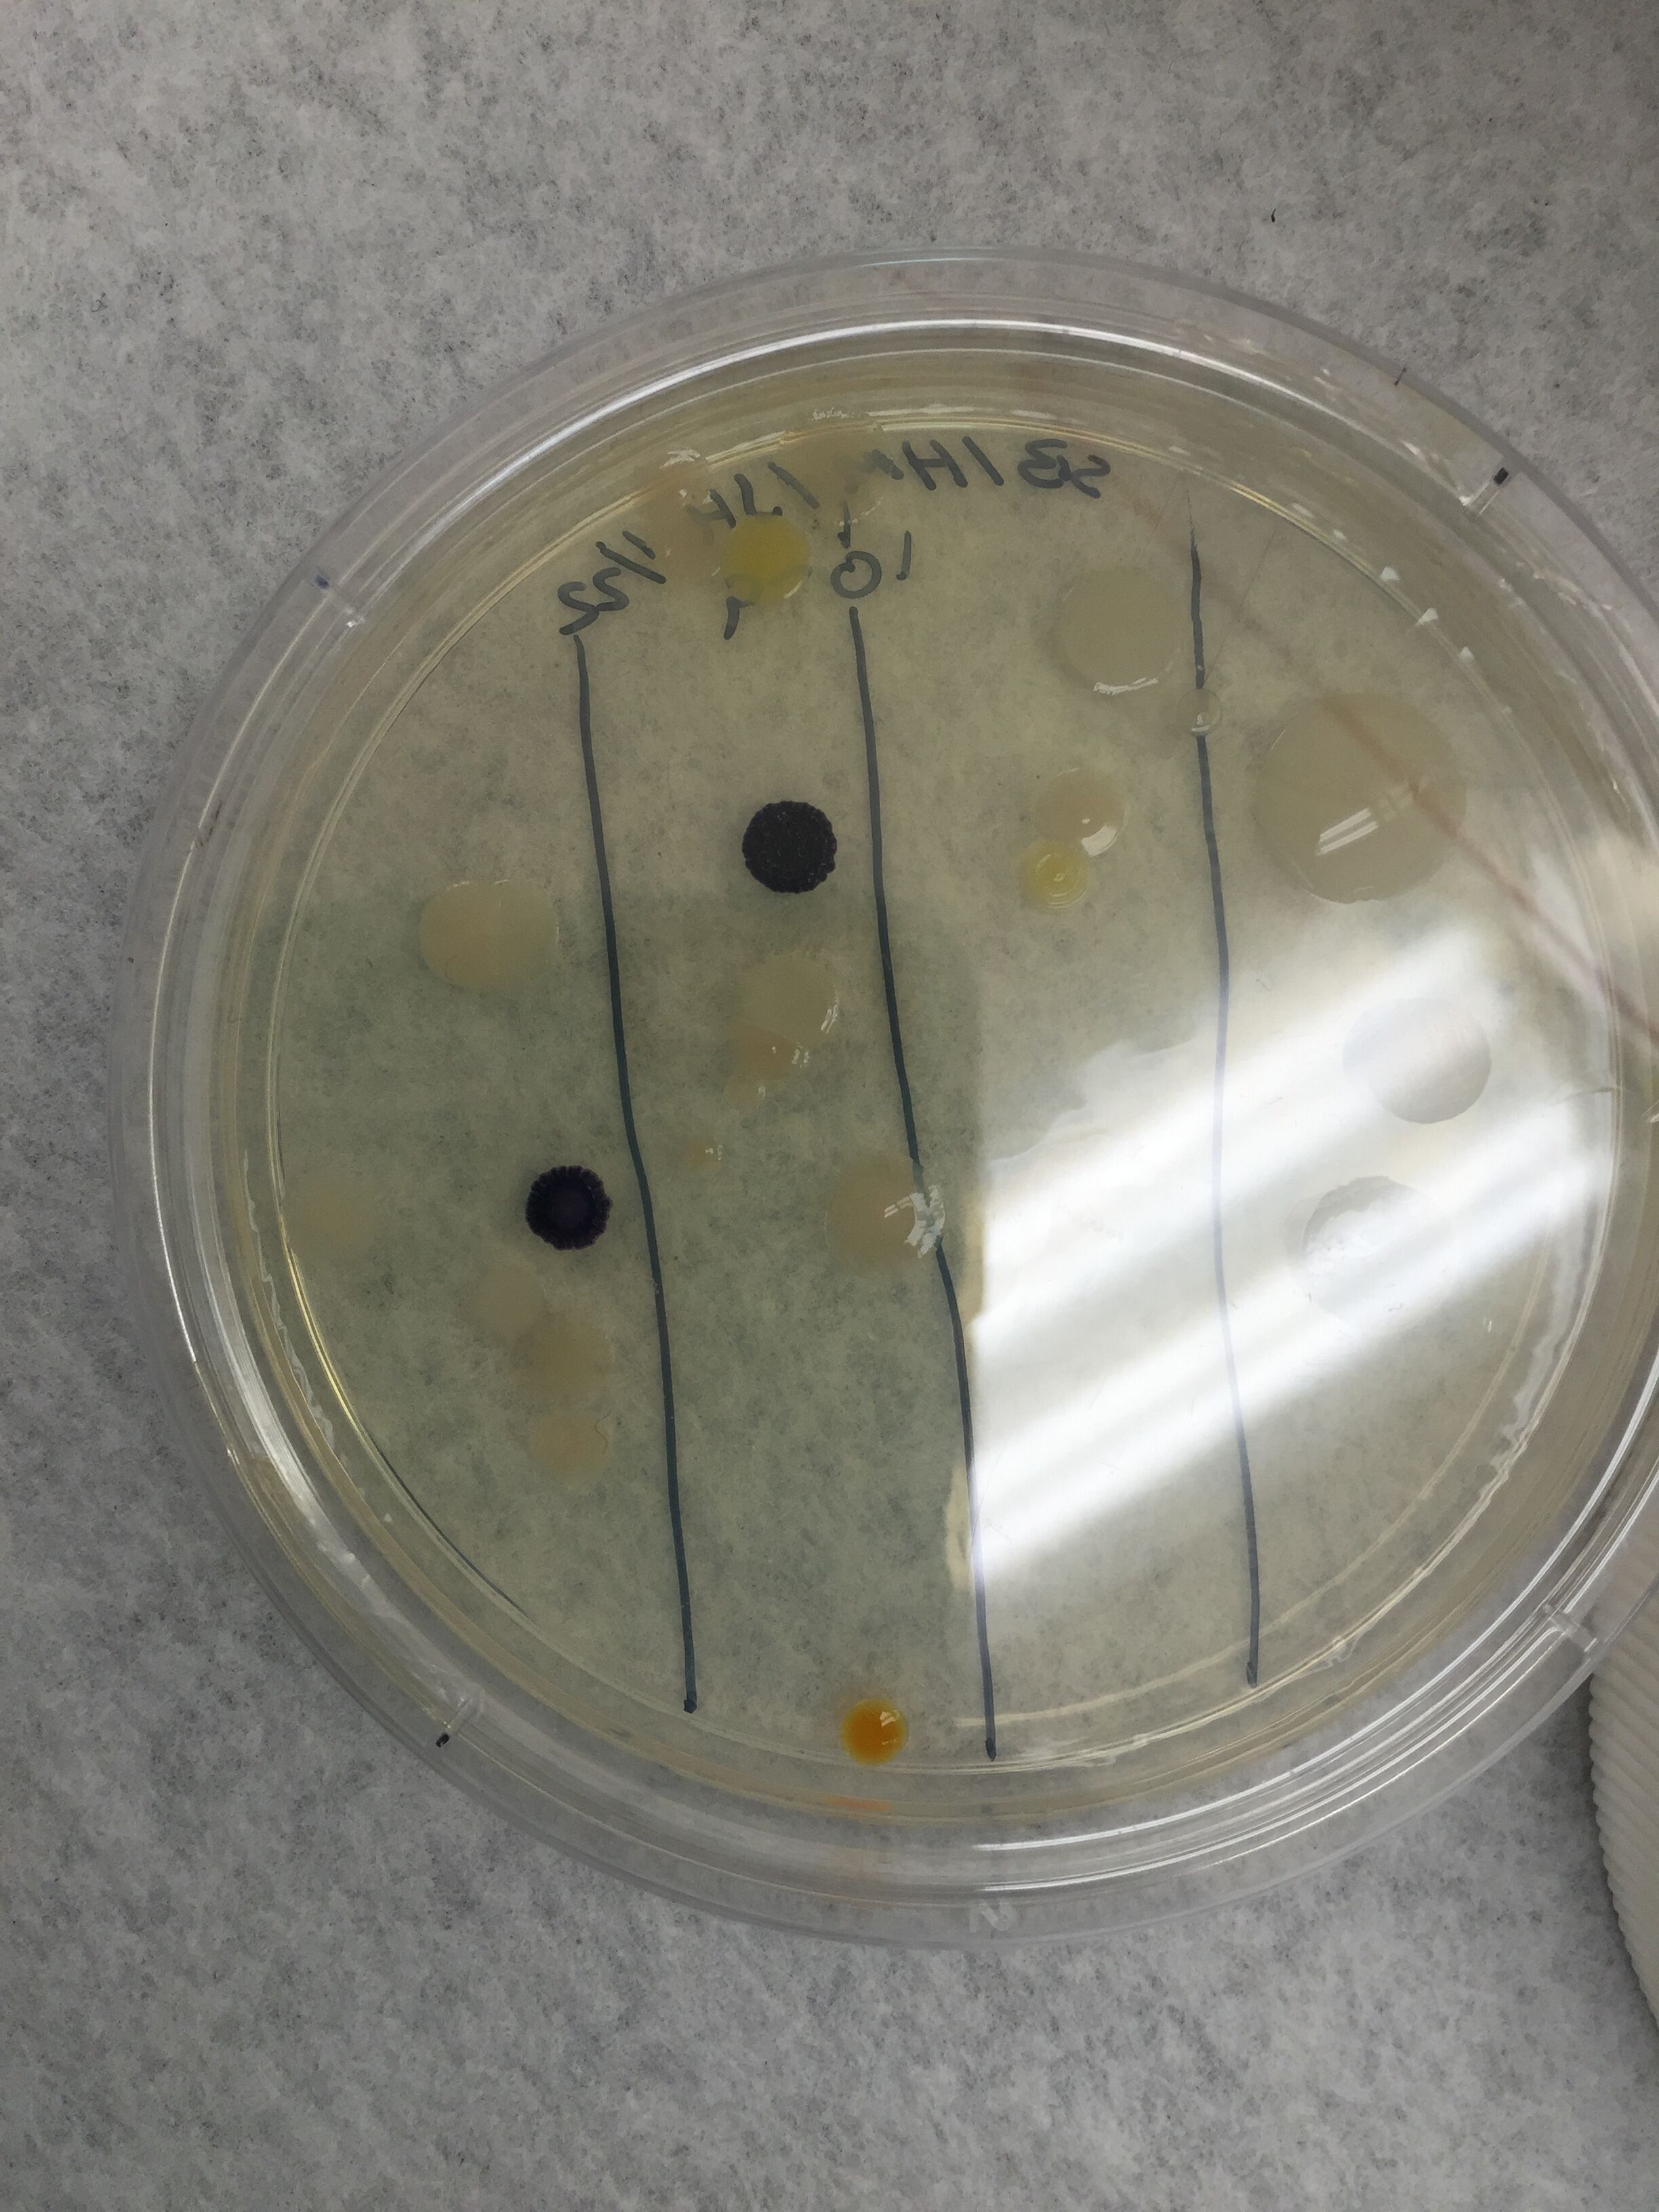

User:Hayley Manke/Notebook/Biology 210 at AU
1/28/16: Transect Characteristics
As a group, a 20 by 20 foot dimension marked by popsicle sticks was observed. We observed Transect 1, which is located on the right side of the Ward Circle Building. Likewise, the transect faces north and is located right off the sidewalk. It was found that the soil near the sidewalk was dry, while the soil near sprinklers, trees or grass was damp. The transect is slightly elevated and there was little vegetation that was alive. There were a plethora of dead leaves and trees scattered throughout the transect. Lastly, right by the sidewalk there was a pile of trash that was composed of receipts, wrappers and a ticket. 
Biotic Factors
1 tree in the northern part of the transect
leaves scattered around the transect
8 patches of grass
dry soil near the side walk
wet soil throughout the transect wherever there are sprinklers present
8-9 Small, dead trees
Abiotic Factors
1 light pole
4 sprinklers
1 pile of trash
1/28/16: Hay Infusion
Week two of lab consisted of observing the organisms present in the hay infusion. To make the hay infusion, we collected 10-12 grams of soil and other ground vegetation from transect 1, and put in a plastic jar with 500 mLs of deerpark water. Then, before mixing it together, dried milk was added. The jar was left open and sat out from week 1 until week 2. Upon initially observing the jar, a strong, foul odor was coming from the ecosystem inside. it smelled of rotten eggs and the water was murky yellow in color. Also there is brown mold and green shoots growing in niche 1 (the top of the jar). In niche 2, there was a dead leaf, dirt and grass blades.

Among the three layers we took samples from, we found three different organisms. We found Gloeocapsa, Arcella and Amoeba. Towards the top of the jar Gloeocapsa was found. In the middle layer Gloeocapsa and Arcella were found. The bottom layer was where Amoeba and Arcella were found. Arcella are protists, while Amoeba and Gloeocapsa are algae. Gloeocapsa are motile, photosynthesizing algae found under wet rocks or wet dirt. When measured with the ocular micrometer, they measured to be five micrometers. They are green in color and are circular in shape. Arcella are also circular in shape, and green but are ten micrometers. Arcella are can be found in mosses and soil. Amoeba under the microscope appeared to be white with green dots and had an abnormal circular shape. Amoeba, just like Arcella, can be found in soil.
Microbiology 2/10/16
In order to learn more about the bacteria living in our transect, we made wet mounts and gram stains for 4 different plates. We used two plates that had Tetracycline present and two plates without the presence of Tetracycline. For this lab, the Tetracycline plates will have dilutions of -3, -5, -7 and -9. Three plates without Tetracycline with dilutions of -3, -5, -7 and -9 are also prepared. To make the wet mounts, we started by sterilizing a loop over a flame form a bunson burner. Then the loop was used to take bacteria from a colony on a plate. The bacteria was placed on a slide with a drop of water. Lastly, a cover slip was added and the slide was observed under a microscope. This wet mount process was used for all of the plates. After wet mounts were prepared, the gram stains were made. Once again to start a loop was sterilized under the flame from a bunson burner and bacteria was taken from a colony on a plate. The bacteria was placed on a slide with a drop of water. A wax marker was used to draw a circle underneath the slide around the bacteria. The slide was then passed through the flame 3-5 times with the bacteria slide facing up. Now the bacteria is covered with crystal violet for one minute and then rinsed with DI water. Gram's Iodine was used to cover the bacteria before being rinsed with DI water again. The slide was then rinsed using 95% alcohol for 10-20 seconds. Safranin red was used to cover the slide fro 10-20 seconds and then rinsed one more time with DI water. Excess water was removed using a kimwipe. All gram stains were made using this process and observed under a microscope.
Final Hay Infusion Observations
-smells like rotten eggs and sulfur -dark yellow water -mold growing across the surface of water
My hypothesis: As time passes, new organisms will develop and grow as the organisms in the infusion compete for resources, which can change the appearance of the hay infusion.
Archaea species may have grown in the transect. Some species can be found in soil and we collected soil samples for our infusion.
Observing Microorganisms
Table 1: Serial Dilution Results
The higher the dilution, the more colonies there would be on the plate. Plates that had Tetracycline present had fewer colonies compared to the plates without Tetracycline. Likewise, the Tetracycline positive plates only had one type of bacteria growing versus the three types growing on the Tetracycline negative plates.
The plates below have Tetracycline with a dilution of -5 and -3.

Both plates had bacteria colonies that were yellow/orange in color, circular, convex, had entire edges and appeared to have a smooth texture.
The plates below do not have Tetracycline added and have dilutions of -7 and -9.

Three types of bacteria grew on these plates. The first type had a colony that is dark purple and circular. The edges are udulate and the surface looked wrinkled. The texture appeared rough and the bacteria colonies were slightly raised. Next, the second type of bacteria was white, had an irregular shape and had entire edges. the surface appeared smooth and raised. Lastly, the third type of bacteria colony was a yellowish color, circular, convex, appeared smooth and had entire edges.
None of the plates had fungus growing on them.
Table 2: Bacteria Characterization
Plant & Fungi 2/18/15
Characteristics of Plant Samples Collected from the Transect
Overall, there was not much variation in the plant life in the transect. Most of the plants in the transect are leaves from the tree, needles from a fern and grasses. The plant life is not flourishing due to the harsh temperatures. This could be the reason why the leaves from the tree are dead and there is not a lot of plants growing.

Invertebrates 2/24/16
In order to identify invertebrates living in our transect, a Berlese Funnel was set up. To set the funnel up, a 25 mL solution of ethanol and water was added to a 50 mL conical tube. A small piece of screen material was taped to the bottom of the funnel to prevent large materials from falling into the ethanol and water solution. Then,parafilm was used to attach the conical tube to the bottom of the funnel. The funnel and conical tube were placed on a ring stand 2 inches below a lamp and leaf litter from the transect was placed in the funnel. Lastly, the funnel was covered with foil and left to sit for about a week.
Invertebrate Characterization Table

3/3/16 Sequencing Data MB14 Sequence
NNNNNNNNNNNNNNNGNNANNNCNTGCNNNNNNANAGGAACGNANTCTTANGNTTCTCGGCAGAGGGGTGAGGGTGCGGT
NAANNNGNGGAAACTGACGTGAGCNGGGGGAAGNNCTTNCCACCGGTANAGTANAACCCCCANATAAAAATCNAGGCAAC
TCTCANTATGAACTGGTCCGGTGGATACAGNAGCNCTCGCCCCAGATGATACANTNGGTAGGGTAACGGCCCCCCACGTC
TGTGATCTTTGTGGGGNCTGANANGNNGATCCCCCACACTGGTACGGANACACGGACCCNACACCTATGGGAGGNGGCTC
AGATGAGCATTGGACNGTGGGTGANNGNNNGATNTGTACANCCNGTCTGNNATTGTANAGCNNTTTGGGTTGGANCNTAT
TTTGNNGCGGGAACATTGNTCGCNNATGTTTCACGCTGAAGNTTNANTTTAAACTCTNTACGNNGNNGCCNNTTATACCA
ACCGTGCACNCATTAATCGNANTTACTGANCNTANAGAATTNNANGTTTTTTGTTANTTGAACNTGAAACCNCGGGCTCA
ACCTGGNACTGCATCCNAAACTGGCCAGCTAGANAAGGTCNANGGTGGTNCAATTTGCTGTGTACCTGTGAATGGNTAAT
ATNTCACGGAACAAGAGTGCCGAATGCNACCNCCGNACGATACTGACACTGANTNCAGCCGCNTGCGAACAAACANNNTT
AGATACCGTGGTNNTCTACGCCTNNGACNANGTCNACTANCANNGGNATCCTTNAGNTNNACTGNCGACCTCANCCNTTA
ATTTGACCNNGGNNNAGTGCNNNNNCANNNNAANNTCNNAGNNATTTNAAGCCGCCCGCACGNGAGGAGGAGCNNGTNGT
TNNNNTNNAANNGCNANAAAAGCTTNGCNNNNCCNNNCNGNGAGNNNANTTTNTTNNNNGNNATNAGTACNNTCNNNNA
There was no match for the MB14 sequence because there was no priming.
MB15 Sequence
NNNNNNNNNNNNNNNNNNNNNAAACNNNNNNNTNNNNNNNGGATCGNGGTNTAGTNNNGNNCTGNNNTGAGGAGTANGGG
AGNNNNNNNNNNNNNAGGNAAACTGCCNGATGGAAGGGGATAACTACNNGNANGGGNANCTAATACCGCACAACGTCNCA
NGACCAAGGAGGGGGACCTTCGGGCCTCTTGCCATCANATGTGCCCAGATGGGATTAGCTNGGAGGTGGGGTAATGGCTC
ACCTAGGCGACGATCCCTANCTGGTCTGANAGGATGACCAGCCACACTGGAACTGAGACACGGTCCACACTCCTACGGGA
GGCAGCANTGGGGAATATTGGGAATGGGCGCAGACCTGATGCGCCATGCCGCGTGTATNANNAACGCCTTCGGGTTNTAA
AGTACTTTCAACGAGGAGGAAGGCATTGAGGTTAATAACCCCNGTGATTGACGTTACTCNCAAAAAAAGCACCAGCTAAT
TCCNTGCCANGCGCCACTANTAATACGTGGNGGCGNNGCNTTAATTTACANTTACNGNGCNTAGAGCACGCGCNNGCGNN
CTTTCAANTCGGAANTNAAGTCCTCCNGCTCAGCCTGGGAACTGCNTTCNAGACTGNNANGCTGNAATCTTGTANAGAGA
ATGTANAATTCCNNATNTAACGGGTGAAATGCNNNGANAGATGAGGGGAATGCCCGTGGGGGCGNGTCGNNCCGNGGTGG
ANAGAGAGTGAGNCTAANGTGCGGGAAGGNTGGAGAGGATGAGAAGGATGCGATAGTCCNNNNNGTCGACNNGNNANACN
ATCTCAANNTNNNNTTNNNGCTCGNNNNNNGTNNCTGTCCGCANNNNAGGAGTTGACNNNGCCGCGCGGTNGAAGAGTAN
NNGANNGTGAAANGCACNGGGAGNTNACNCGAGCCGCCGNANNANGNGNTNTAACTTGTANGTTNNTTAGNAGNGCGNGN
GNTGNNCATNNGCGCNNGACAGGATTCCCGCNGNGGNGAG
There was a match for this PCR. The genus it comes from is bacteria and it was named uncultured bacteria or environmental sample. In bacteria, the 16 rRNA gene is specific to each species. The first sequence did not show any result. The other sample supported that the colony we collected from is indeed bacteria.
Vertebrate analysis and food web 3/17/16
There were no vertebrates found in transect 1. This is most likely due to the harsh weather conditions and over exposure to humans. We studied the transect during winter when there was low temperatures and a lot of snow. Vertebrates that can inhabit this transect include: rats, insects, squirrels, birds or deer. They probably moved to a more suitable habitat due to the transect's exposure to humans and the location being close to a road.
Food Web for Vertebrates: insects--> rats--> squirrels--> birds--> deer







